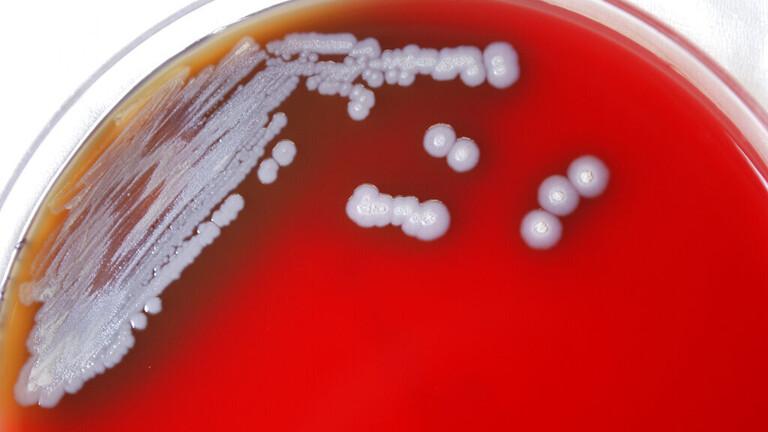

أفريقيا برس – تونس. قال المركز الأمريكي للسيطرة على الأمراض والوقاية منها إنه تم اكتشاف نوع من البكتيريا القاتلة التي وجدت سابقا فقط في جنوب آسيا وإفريقيا وأستراليا، بعينات التربة والمياه الأمريكية.
وأوضح المركز أن هذه البكتيريا Burkholderia pseudomallei، يمكن أن تسبب مرضا يسمى داء الكَلْم، والذي ثبت أنه قاتل في نصف الحالات في جميع أنحاء العالم، مشيرا إلى أنها كانت موجودة سابقا فقط في أجزاء من جنوب آسيا أو إفريقيا أو أستراليا، ومن غير الواضح كم من الوقت بقيت البكتيريا في البيئة وأين يمكن العثور عليها في الولايات المتحدة.
وأفاد بأنه يتم اكتشاف حوالي 12 حالة كل عام في الولايات المتحدة، عادة بين الأشخاص الذين سافروا إلى الخارج، معلنا أنه تم العثور على البكتيريا في عينات التربة والمياه على طول ساحل الخليج في ميسيسيبي، وتم إصدار تنبيها صحيا للأطباء في جميع أنحاء البلاد ليبحثوا عن أعراض مرض الكَلْم، والتي يمكن أن تكون غامضة، لكنها تتضمن السعال والحمى وآلام الصدر. أما في الحالات الأكثر شدة، يمكن أن يؤدي المرض إلى أمراض رئوية ونوبات.
يمكنكم متابعة المزيد من أخبار و تحليلات عن تونس اليوم عبر موقع أفريقيا برس